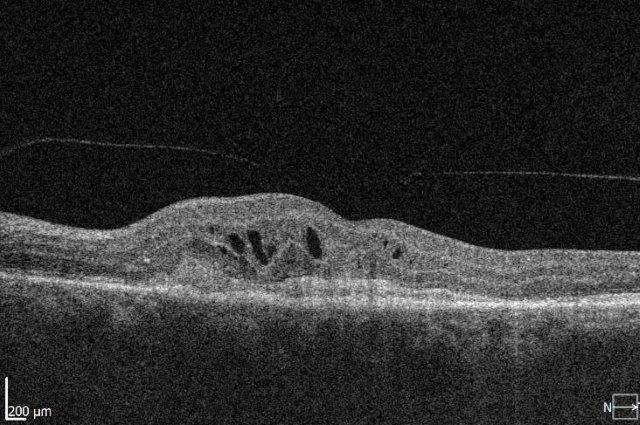
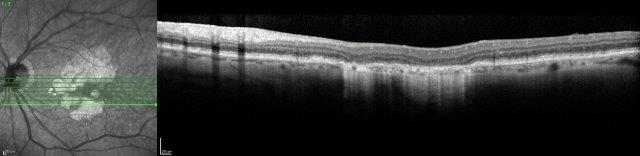

Established and emerging trends in AMD management
One of the most exciting facets of being medical retina specialists is the continued evolution of age-related macular degeneration (AMD) therapies. We have come a long way from the days of photodynamic therapy and the fledgling anti-vascular endothelial growth factor (anti-VEGF) which was Macugen (pegaptanib sodium). We now have agents able to restore and maintain vision with neovascular AMD (nAMD) and agents potentially capable of stabilising atrophic AMD. This article provides an overview of established and emerging treatments.
Existing and newer agents for nAMD management
Anti-VEGF treatment continues to be the mainstay of treatment of nAMD in New Zealand. The initial agent used for most patients is bevacizumab 1.25 mg (Avastin), with access pathways to aflibercept 2mg (Eylea) in cases of non-response to treatment and ranibizumab 0.5mg (Lucentis) if certain criteria are met. Avastin and Lucentis are monoclonal antibodies to VEGF, whereas Eylea is a VEGF trap. The benefits of these agents are well established, but long-term challenges remain in maintaining the visual gains and in the burden of frequent injections for both the patient and eye clinics.
Advances in nAMD management came with the development of more durable anti-VEGF treatments requiring less frequent dosing and exploring different dosing regimens of existing agents. Of these, faricimab (Vabysmo) shows a lot of promise and targets both VEGF and angiopoetin-2, preventing them from binding with their respective receptors. The Tenaya and Lucerne phase 3 (industry sponsored) clinical trials compared Vabysmo with aflibercept in patients with naive nAMD (who had not been treated with other agents)1. Patients were randomised to either Vabysmo monthly for four injections, then at individualised treatment intervals up to 16 weeks, or aflibercept 2mg with three initial monthly injections followed by an injection every eight weeks. In both studies, Vabysmo was non-inferior to aflibercept in terms of visual acuity criteria. At two years, 80% of patients treated with Vabysmo were on 12-weekly intervals and 63% were stable on 16-weekly intervals. Intraocular inflammation developed in 2% of Vabysmo cases compared to 1.2% of aflibercept, but there were no cases of retinal vasculitis. As faricimab blocks both the VEGF and ang-2 pathway, it has been shown to provide greater vascular stability (as evidenced by a greater and faster resolution of macular leakage). This reduction in leakage, not seen with straight VEGF blockade, is important as leakage can lead to increased fibrosis and reduced vision.
Real-world studies Truckee and Faretina retrospectively analysed data from sight registries for Vabysmo’s efficacy and safety. They indicated the majority of eyes previously treated with other anti-VEGF agents and switched to Vabysmo were able to extend their treatment interval with maintenance of visual acuity2,3. In treatment-naive eyes there was acuity improvement and extension. Longer-term follow up will be needed to fully establish the role of Vabysmo in nAMD management worldwide but safety data from real world studies so far are reassuring2,4.
Higher doses of aflibercept (8mg) are being evaluated in the Pulsar and Candela trials. It is important to note the higher doses are more concentrated without an increase in volume. The Pulsar study (industry sponsored) showed 8mg dosing was safe and had longer duration of effect, with 79% (n=316) able to maintain 12-weekly treatment intervals and 77% (n=312) 16-weekly intervals5. The phase 2 results of Candela have not shown statistically significant anatomical improvements compared to the 2mg dose at week 16, but safety profiles were similar for the two doses6.
Brolucizumab (Beovu) is another nAMD treatment and is an antibody fragment targeted against VEGF-A. It is approved by Australia’s Therapeutic Goods Administration and the US Food and Drug Administration, with phase 3 clinical trials showing non-inferiority to aflibercept with reduced injection frequency and better anatomical outcomes (Hawk and Harrier studies)7. However, post-hoc studies showed a higher than expected incidence of intraocular inflammation, including cases of severe uveitis and retinal vasculitis, which led to early termination of three further studies. Further real-world data on this will be useful. Currently brolucizumab, faricimab and high-dose aflibercept are all unfunded in New Zealand and are not Medsafe listed.
Other agents to be aware of are ‘biosimilars’. These contain the same therapeutic agent as the original drug but often use a different delivery vehicle, meaning they won’t necessarily have an equivalent therapeutic or side-effect profile. For example, they may have different osmolarity, which would result in different risks of inflammation. These drugs have the potential to be cost-saving if their efficacy and safety is proven. Ziv-aflibercept (Zaltrap), for example, is used by many retinal doctors in New Zealand in cases where Eylea is not funded, as with macular oedema due to vascular occlusions.
There are many other potential targets for nAMD under investigation, including tyrosine kinase inhibitors and gene therapies. These may also have potential for reducing treatment burden. Examples include ADVM-022, an intravitreal injection of codon-optimised cDNA expressing an aflibercept-like protein which has shown promise in pre-clinical models and involves a single injection8.
Optimising treatment regimens
Initial clinical trials showed that anti-VEGF treatment led to stability of vision in about 90% of patients, but in the real world the results are poorer and vision can decline over time. The Fight Retinal Blindness! (FRB!) project reported five-year data of 302 patients treated for nAMD and reassuringly found stability of vision in the first affected eyes after five years of treatment (p=0.01). However, half of the patients developed second eye involvement in the study period; these eyes received fewer treatments and did lose a mean of 5.8 letters9. The main reason for patients losing vision with time is development of scarring (fibrosis) or atrophy (Fig 1). Atrophy develops in around 40% of patients within five years of nAMD treatment and is not amenable to anti-VEGF treatment10. In contrast, subretinal fibrosis is a consequence of the neovascular process and anti-VEGF treatment aims to limit or prevent development and expansion with time. Certain subtypes of nAMD, particularly predominantly classic membranes, have higher risk of fibrosis11. Newer agents targeting fibrosis should hold promise.
Fig 1. Subretinal fibrosis following delayed presentation of nAMD
Under-treatment of nAMD increases the risk of fibrosis, but many challenges exist with current agents and the frequency of injections required, impacting the patient’s ability to attend appointments and the clinic’s ability to provide timely care. Newer treatments with longer duration of effect may be helpful in improving patient adherence but there are other challenges to be considered. These include adequate funding of a health system to develop the staff and facilities to monitor and administer treatments and, ideally, more eye clinics administering injections in different geographical regions. The ability to access treatment promptly is equally important, to limit the initial damage from fibrosis or haemorrhage. Initiatives such as fast-track macular clinics or funded optometrist visits could help with this.
Weaning treatments when patients stabilise must also be done with care. Several studies have shown a significant risk of recurrence following cessation of anti-VEGF injections. The FRB! project showed 50% have recurrence by 12 months and 75% by four years, providing large-scale real-world data that are outside a study setting12. High levels of recurrence have similarly been reported in other studies13. The FRB! data were sobering, since not all patients returned to their previous baseline level of vision after a recurrence, but other studies have not confirmed this.
Emerging treatments for dry macular degeneration
Several therapeutic approaches have been investigated for dry AMD and are in different stages of clinical trials, but as yet there is no agent that is shown to be a real ‘game-changer’ in management. One of the main goals is to find treatments that prevent or limit geographic atrophy (GA). This is the advanced stage of dry AMD characterised by loss of retinal photoreceptors, retinal epithelium and choriocapillaris. When seeing patients with dry AMD it is important to get good baseline data to characterise the extent of the disease and monitor progression, including autofluorescence photography and OCT scans (Figs 2 and 3).
Fig 2. A 72-year-old male’s atrophic AMD. Infrared and OCT images indicating cRORA.
Credit: Dr Oliver Comyn and the Christchurch Archer trial group
Some of the treatments under development include those targeting the complement pathway, senolytic therapy and gene therapy. Study results have been released for the complement inhibitor pegcetacoplan (Empaveli, Filly trial), which is administered by intravitreal injection and inhibits C3. This is the first study showing that GA progression can be slowed. However, the benefits of treatment compared to observation only became apparent after 18 months of monthly injections. Post-hoc analysis demonstrated reduction in progression from precursors of GA, or incomplete retinal pigment epithelium (RPE) and outer retinal atrophy (iRORA) to GA, also classified as complete outer RPE and outer retinal atrophy (cRORA)14. Overall, 81% of sham eyes showed progression from iRORA to cRORA, compared with 50% in the monthly pegcetacoplan group. There have been some significant adverse effects reported, including occlusive retinal vasculitis and non-arteritic ischaemic optic neuropathy. These reports are recent and under urgent review15.
Other complement inhibitors being studied are avacincaptad pegol (Izervay), another intravitreal agent which inhibits cleavage of C5 into C5a and C5b, with the Gather study demonstrating reduction of GA growth by 30% after monthly injections16. Other pathways for dry AMD research include senolytic treatments targeting senescence/ageing, and gene therapies such as GT-005, which acts by targeting the complement factor 1 (CF1) gene.
While these treatments show promise, and it is exciting to have proof that GA can be slowed, the treatment burden associated would be very large and ongoing.
Supportive measures and summary
As healthcare providers it is easy to become focused on active interventional therapies, but we should also be mindful of the benefits of prevention and adjunctive supportive treatments. For instance, knowledge of family history and genetic risk can influence and modify lifestyle choices. Education and support remains important, not only for the patient but for their whānau and community, and is the focus of organisations such as Macular Degeneration New Zealand and support networks in the form of the Blind Low Vision NZ and low vision clinics. AMD is a disease with the potential to significantly impact quality of life and independence, but this is an exciting time in AMD management, with access to a range of proven treatments. New agents showing the potential for disease stability with reduced treatment burden and active treatments for our patients with dry AMD are getting closer.
References
- Heier J, Khanani A et al. Efficacy, durability and safety of intravitreal faricimab up to every 16 weeks for neovascular age-related macular degeneration (TENAYA and LUCERNE): two randomized, double-masked, phase 3, non-inferiority trials. Lancet, 2022.
- Khanani A, Aziz A, et al. The real-world efficacy and safety of faricimab in neovascular age-related macular degeneration: the TRUCKEE study - 6 month results. Eye (Lond). 2023 May 12. Epub ahead of print. PMID: 37173428.
- Borkar D, Tabano D et al. Early treatment patterns and outcomes in patients with neovascular age-related macular degeneration initiating faricimab: the FARETINA-AMD study. Presented ASRS oral presentation Seattle Aug 2023.
- Rush R, Rush S. Intravitreal faricimab for aflibercept-resistant neovascular age-related macular degeneration. Clin Ophthalmol. 2022 Dec.
- Intravitreal aflibercept 8mg injection in patients with neovascular degeneration: 48 -week results from the Phase 3 PULSAR trial. ARVO Annual meeting abstract June 2023.
- Wkykoff C, Brown D et al. Effect of high-dose intravitreal aflibercept 8mg in patients with nAMD: the phase 2 CANDELA randomized clinical trial. JAMA Ophthalmol 2023 Aug.
- Regillo C, Singh R et al. Fluid control in neovascular age-related macular degeneration with brolucizumab: an analysis of the HAWK and HARRIER phase 3 trials. Ophthalmologica 2022, 245, 403-412
- Khanani A, Thomas M et al. Review of gene therapies for age-related macular deneration. Eye (Lond) 2022 Feb; 36(2): 303-311
- Cornish E, Teo K et al. Five-year incidence and visual acuity outcomes for intravitreal therapy in bilateral neovascular age-related macular degeneration: Fight Retinal Blindness! Project. Retina 2021 jan1; 41(1):118-124
- Daien V, Nguyen V et al. Prevalence and characteristics of macular atrophy in eyes with neovascular age-related macular degeneration. A study from a long-term observational dataset: the Fight Retinal Blindness! Project. Br J Ophthal 2020; 104(8): 1064-69
- Adrean S, Morgenthien E et al. Subretinal fibrosis in HARBOR varies by choroidal neovascularization subtype. Ophthalmol Retina 2020; 4(7): 752-4
- Nguyen V, Vaze A et al. Outcomes of suspending anti-VEGF inhibitors for neovascular age-related macular degeneration when lesions have been inactive for 3 months. FRB! Study group. Ophthal 2019; 3(8): 623-628
- Arendt P, Yu S et al. Exit Strategy in a treat-and-extend regimen for exudative age-related macular degeneration. Retina 2019; 39:27-33
- Nittala M, Metlapally R et al. Association of pegcetacoplan with progression of incomplete retinal pigment epithelium and outer retinal atrophy in age-related macular degeneration. A post hoc analysis of the FILLY randomized clinical trial. JAMA Ophthalmol 2022; 140(3): 243-249
- Apellis provides updates on injection kits and rare safety events with Syfovre (pegcetacoplan injection). Apellis. Press Release. August 22, 2023.
- Jaffe G, Westby K et al. c5 inhibitor avacincaptad pegol for geographic atrophy due to age-related macular degeneration: A randomized pivotal phase 2/3 trial. Ophthalmology 2021; 128(4): 576-586

Dr Jo Sims is a medical retina and uveitis specialist at Eyes and Eyelids and Greenlane Clinical Centre in Auckland. She is a trustee for Macular Degeneration NZ and is on the Pharmac Ophthalmology Subcommittee.

Dr Ainsley Morris is passionate about all things medical retina. She runs EyeAM, a happy and thriving practice in Christchurch, is a trustee for Macular Degeneration NZ and actively participates in AMD research.






















